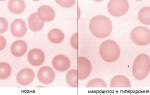

Причины бигеминии и тригеминии
Обычные единичные предсердные и желудочковые экстрасистолы могут встречаться даже у здоровых людей. Обычно они не вызывают ощущений и дискомфорта. Однако более частые экстрасистолы, такие как аллоритмия, парные экстрасистолы и эпизоды желудочковой тахикардии, не являются нормой и требуют тщательного обследования сердечно-сосудистой системы.
Основными факторами, способствующими возникновению бигеминии и тригеминии, являются:
- Острые инфаркты миокарда,
- Передозировка сердечными гликозидами (гликозидная интоксикация), связанная с препаратами наперстянки и дигиталиса, такими как строфантин, дигоксин, коргликон и другие,
- Приобретенные пороки митрального и аортального клапанов,
- Перенесенная ревматическая лихорадка (ревматизм), приводящая к поражению внутренней оболочки сердца – эндокардиту,
- Последствия миокардита – воспалительного процесса в сердечной мышце; даже незначительные рубцовые изменения могут стать причиной патологической циркуляции импульсов по миокарду,
- Постинфарктный кардиосклероз (ПИКС) – рубцовые изменения в нормальной структуре миокарда.
Если после полного обследования у пациента не выявлено органического поражения миокарда, вероятной причиной бигеминии и тригеминии являются нарушения вегетативного контроля над сердцем, связанные с вегето-сосудистой дистонией. В таком случае необходима консультация невролога.
Врачи отмечают, что бигеминия и тригеминия, представляющие собой желудочковые аллоритмии, могут возникать по различным причинам, включая сердечно-сосудистые заболевания, стресс и электролитные нарушения. Симптомы часто включают учащенное сердцебиение, чувство перебоев в работе сердца и, в некоторых случаях, головокружение. Диагностика этих состояний обычно осуществляется с помощью электрокардиограммы (ЭКГ), которая позволяет выявить характерные изменения в ритме сердца. Лечение может варьироваться в зависимости от причины и тяжести состояния. Врач может рекомендовать изменения в образе жизни, медикаментозную терапию или, в более сложных случаях, инвазивные процедуры. Важно, чтобы пациенты не игнорировали симптомы и своевременно обращались за медицинской помощью, так как это может предотвратить развитие серьезных осложнений.

Симптомы бигеминии и тригеминии
Симптомы экстрасистолии, проявляющиеся в виде би- или тригеминии, включают кардиологические и неврологические проявления.
Пациенты часто ощущают ритмичные толчки в области сердца, чередующиеся с ощущением его остановки или замирания. Это соответствует компенсаторной паузе, фиксируемой на ЭКГ. Также могут возникать внутренние дрожь, нехватка воздуха и дискомфорт в груди, который может быть давящим или жгучим.
Эти ощущения связаны с нарушением нормального цикла сердечного сокращения, что приводит к недостаточному кровоснабжению головного мозга. В результате пациенты могут испытывать вялость, сонливость, появление мушек перед глазами и предобморочные состояния. В редких случаях возможен кратковременный обморок, особенно если аллоритмия сопровождается другими нарушениями сердечного ритма.
При наличии подобных симптомов, особенно если они сопровождаются изменениями артериального давления, пациенту настоятельно рекомендуется обратиться за медицинской помощью, будь то в поликлинике или через службу скорой помощи.
| Характеристика | Бигеминия | Тригеминия |
|---|---|---|
| Определение | Нарушение ритма сердца, при котором за каждым нормальным комплексом QRS следует преждевременный желудочковый комплекс (ЖПВ). | Нарушение ритма сердца, при котором за каждым нормальным комплексом QRS следуют два преждевременных желудочковых комплекса (ЖПВ). |
| Возникновение | Часто обусловлено органическими заболеваниями сердца (ИБС, кардиомиопатии), электролитными нарушениями, воздействием лекарственных препаратов (например, сердечные гликозиды), стрессом. | Аналогично бигеминии, часто обусловлено органическими заболеваниями сердца, электролитными нарушениями, воздействием лекарственных препаратов, стрессом. Более тяжелое нарушение ритма, чем бигеминия. |
| Симптомы | Может протекать бессимптомно, либо проявляться ощущением сердцебиения (пароксизмальной тахикардии), перебоями в работе сердца, слабостью, головокружением, обмороками (в тяжелых случаях). | Более выраженные симптомы, чем при бигеминии: выраженное ощущение сердцебиения, перебои в работе сердца, слабость, головокружение, обмороки, одышка, боль в груди (в тяжелых случаях). |
| Диагностика | Электрокардиография (ЭКГ) – основной метод диагностики, выявляющий преждевременные желудочковые комплексы (ЖПВ) и их морфологию. Дополнительные методы: суточное мониторирование ЭКГ (холтер), эхокардиография. | Электрокардиография (ЭКГ) – основной метод диагностики, выявляющий преждевременные желудочковые комплексы (ЖПВ) и их морфологию. Дополнительные методы: суточное мониторирование ЭКГ (холтер), эхокардиография, коронарография (при подозрении на ИБС). |
| Лечение | Лечение зависит от причины и тяжести симптомов. Может включать коррекцию электролитных нарушений, отмену провоцирующих лекарственных препаратов, лечение основного заболевания сердца (например, антиангинальная терапия при ИБС), β-блокаторы, антиаритмические препараты (в тяжелых случаях). В некоторых случаях показана имплантация кардиовертера-дефибриллятора (КД). | Лечение аналогично бигеминии, но чаще требуется более агрессивная терапия, включая антиаритмические препараты, β-блокаторы, в тяжелых случаях – имплантация кардиовертера-дефибриллятора (КД), абляция. |
Диагностика
Диагностика бигеминии и тригеминии становится ясной после выполнения электрокардиограммы (ЭКГ).
Если пациент жалуется на периодические симптомы, но на ЭКГ фиксируются лишь отдельные экстрасистолы, ему необходимо пройти суточное мониторирование артериального давления и ЭКГ (по методу Холтера). Это позволит “поймать” экстрасистолию, оценить её по шкалам Райан или Лаун и получить прогностическую классификацию экстрасистол.
При подтверждении бигеминии или тригеминии требуется полное обследование для определения причины аритмии. В дополнение к основным методам диагностики могут быть назначены:
- Общие и биохимические анализы крови для исключения воспалительных процессов и оценки липидного профиля, что поможет выявить атеросклероз и ишемическую болезнь сердца.
- Ультразвуковое исследование сердца (Эхо-кардиоскопия) для обнаружения структурных или морфологических изменений в сердечной мышце.
- Тесты с физической нагрузкой (тредмил-тест, проба с шестиминутной ходьбой, велоэргометрия) для оценки влияния физических нагрузок на развитие бигеминии и тригеминии, а также для анализа переносимости нагрузок при ишемии или хронической сердечной недостаточности.
Бигеминия и тригеминия — это виды желудочковых аллоритмий, которые могут вызывать беспокойство у пациентов. Эти состояния характеризуются чередованием нормальных сердечных сокращений с дополнительными, что может приводить к ощущению перебоев в работе сердца. Возникновение таких аритмий часто связано с различными факторами, включая стресс, физическую нагрузку, употребление кофеина или алкоголя, а также наличие сердечно-сосудистых заболеваний.
Симптомы бигеминии и тригеминии могут варьироваться от легкого дискомфорта до выраженной тахикардии, одышки и даже обмороков. Для диагностики этих состояний врачи используют электрокардиограмму (ЭКГ), которая позволяет зафиксировать характерные изменения в сердечном ритме.
Лечение может включать изменение образа жизни, медикаментозную терапию или, в некоторых случаях, более инвазивные методы. Важно, чтобы пациенты не игнорировали симптомы и обращались за медицинской помощью, чтобы избежать возможных осложнений.

Видео: бигеминия на ЭКГ
Лечение
Если у пациента исключены органические патологии сердца как причина бигеминии и тригеминии, ему следует обратиться к неврологу для лечения вегето-сосудистой дистонии.
Прежде всего, важно скорректировать образ жизни, обеспечив полноценное питание и сбалансированный режим труда и отдыха. Необходимо нормализовать психологическое состояние пациента и создать комфортные условия для его психоэмоционального состояния. Эффективными методами тренировки сердечно-сосудистой системы являются контрастные души, обливания и растирания влажной тканью.
Если у пациента выявлено заболевание сердца, оно требует обязательного лечения. В некоторых случаях может потребоваться хирургическая коррекция сердечного порока.
Помимо основного лечения, пациенту назначаются бета-адреноблокаторы для постоянного применения, такие как соталол, небилет, коронал, конкор и другие, а также блокаторы кальциевых каналов, например, дилтиазем и верапамил. Эти препараты помогают снизить частоту сердечных сокращений и уменьшить проводимость патологических импульсов в миокарде желудочков.
Для неотложной помощи при внезапной частой бигеминии или тригеминии применяются кордарон, лидокаин и хинидин для внутривенного введения.
Если антиаритмическая терапия противопоказана, плохо переносится или оказывается неэффективной, следует рассмотреть возможность проведения радиочастотной аблации (РЧА) — процедуры, направленной на прижигание ткани предсердия или желудочка, по которым проходит патологическая импульсация.

Возможны ли осложнения бигеминии и тригеминии?
Осложнения могут возникнуть у пациентов с любыми формами экстрасистолии — как предсердной, так и желудочковой.
Предсердная экстрасистолия может привести к мерцанию или трепетанию предсердий. Желудочковая бигеминия или тригеминия, в свою очередь, могут вызвать желудочковую тахикардию, фибрилляцию желудочков и даже асистолию (остановку сердца). Чтобы предотвратить осложнения, важно своевременно начинать лечение заболеваний, способствующих развитию бигеминии и тригеминии.
Прогноз
Единичные экстрасистолы обычно не представляют опасности при отсутствии органических заболеваний сердца. В отличие от них, парные и групповые экстрасистолы могут привести к пароксизмам желудочковой тахикардии.
Прогноз для бигеминии и тригеминии определяется классификацией экстрасистолии по Лаун (Lown):
- 1 класс – менее 30 одиночных экстрасистол в час,
- 2 класс – более 30 одиночных экстрасистол в час,
- 3 класс – полиморфные (разных форм) и политопные (из различных участков миокарда желудочков) экстрасистолы,
- 4А класс – парные экстрасистолы,
- 4Б класс – групповые экстрасистолы,
- 5 класс – “ранние” экстрасистолы, возникающие на фоне продолжающегося нормального сокращения сердца.
Таким образом, прогноз для первых двух классов благоприятный. Например, если у пациента в течение часа фиксируется несколько экстрасистол, которые регулярно чередуются с нормальными сокращениями сердца через одно или два сокращения. Третий-пятый классы имеют неблагоприятный прогноз из-за высокого риска серьезных нарушений ритма. Это означает, что бигеминия и тригеминия, чередующиеся с парными, групповыми или ранними экстрасистолами, могут представлять опасность из-за возможных осложнений.
В заключение, экстрасистолия в виде бигеминии и тригеминии становится опасной только при наличии серьезной патологии миокарда. В противном случае, например, при вегето-сосудистой дистонии, такие экстрасистолы исчезают после нормализации влияния вегетативной нервной системы на сердце.
Вопрос-ответ
Что такое бигеминия и тригеминия?
Бигеминия — после каждого нормального сокращения следует экстрасистола. Тригеминия — за двумя основными комплексами следует одна экстрасистола, или за одним очередным комплексом следует две экстрасистолы. Квадригеминия — экстрасистола следует после каждых трёх нормальных сокращений.
Какие препараты убирают экстрасистолы?
Как правило, для лечения этого вида аритмии назначают новокаинамид, лидокаин, хинидин, кордарон, мексилен, соталол, дилтиазем. А также препараты калия и магния.
От чего могут быть желудочковые экстрасистолы?
Желудочковые экстрасистолы могут появиться при интоксикации сердечными гликозидами, передозировке трициклическими антидепрессантами, эуфиллином, амитриптилином, флуоксетином, при применении антиаритмических препаратов.
Советы
СОВЕТ №1
Если вы заметили у себя симптомы, такие как учащенное сердцебиение, головокружение или слабость, не откладывайте визит к врачу. Раннее обращение за медицинской помощью поможет установить точный диагноз и начать необходимое лечение.
СОВЕТ №2
Следите за своим образом жизни: регулярные физические нагрузки, сбалансированное питание и отказ от вредных привычек могут значительно снизить риск возникновения желудочковых аллоритмий. Уделяйте внимание своему психоэмоциональному состоянию, избегая стрессов.
СОВЕТ №3
Регулярно проходите медицинские обследования, особенно если у вас есть предрасположенность к сердечно-сосудистым заболеваниям. ЭКГ и другие диагностические процедуры помогут выявить возможные нарушения на ранних стадиях.
СОВЕТ №4
Обсудите с врачом возможность применения медикаментозного лечения или других терапевтических методов, если у вас уже диагностированы бигеминия или тригеминия. Не занимайтесь самолечением и следуйте рекомендациям специалиста.